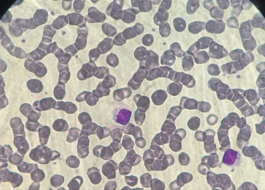

NOTICIAS DE LA PROVINCIA
Buscador de noticias
- QUILMESKicillof recorrió los barrios Sayonara y La Matera, junto a los ministros Leonardo Nardini y Cristina Álvarez Rodríguez; la intendenta Mayra Mendoza; y la candidata Victoria Tolosa Paz.Martes 2 de Noviembre 2021
- CapacitaciónEn el teatro de Luz y Fuerza, la ministra hizo hincapié en la importancia de la formación para la inserción laboral.Lunes 1 de Noviembre 2021
- Vacunación COVIDAsí lo demuestra la investigación desarrollada por la Unidad Coronavirus del Ministerio de Ciencia, Tecnología e Innovación junto al Ministerio de Salud bonaerense y Salud de Nación.Lunes 1 de Noviembre 2021